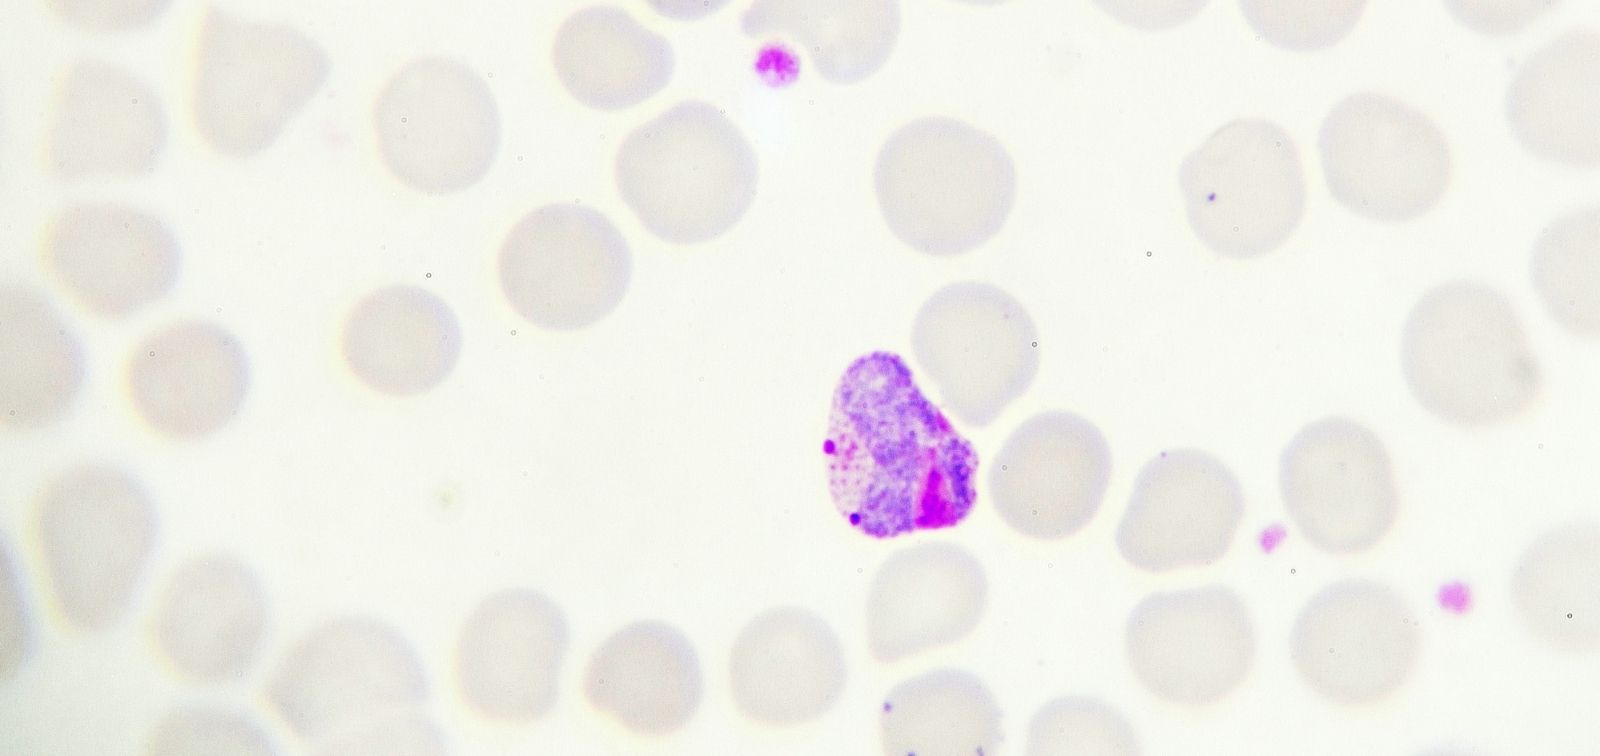

GlycoTargets
Noves teràpies antimalàriques dirigides contra les vies de glicosilació de 'Plasmodium falciparum'
- Durada
- 01/09/2024 - 31/08/2026
- Coordinador
- Luis Izquierdo Lázaro
- Finançadors
- Ministeri de Ciència i Innovació - Agència Estatal d'Investigació
La malària és un greu problema de salut global que causa la mort de més de 600.000 persones a l'any —principalment infants menors de cinc anys i dones embarassades a l’Àfrica subsahariana—, sent el paràsit Plasmodium falciparum l’espècie causant de la forma més greu de la malaltia i la responsable del major nombre de morts.
Cal destacar que la malària és una malaltia prevenible i curable, i les teràpies combinades amb artemisinina són una de les principals eines per al seu control. No obstant això, l’extraordinària plasticitat metabòlica de P. falciparum fa que el paràsit sigui propens a desenvolupar resistències a tots i cadascun dels tractaments descoberts. De fet, la resistència a l’artemisinina comença a aparèixer a la subregió del Gran Mekong, cosa que subratlla la urgent necessitat de desenvolupar noves eines i teràpies per combatre la malaltia.
Resultats recents del grup de Glicobiologia i Biologia del Paràsit de la Malària i d’altres grups de recerca confirmen que els glicoconjugats exerceixen funcions fonamentals en el desenvolupament de P. falciparum. De fet, el paràsit sembla ser especialment sensible a l’alteració d’aquests mecanismes de glicosilació, segons dades de diverses fonts. La nostra hipòtesi és que certes vies de glicosilació, com ara la via de biosíntesi de les hexosamines (HBP), la biosíntesi de glicosilfosfatidilinositol (GPI) i la N-glicosilació, podrien ser excel·lents objectius no explorats per idear noves estratègies que aturin el creixement del paràsit.
L’HBP és una via lateral de la glucòlisi que genera uridina di-fosfat-N-acetilglucosamina (UDP-GlcNAc), un sucre nucleòtid essencial en el desenvolupament del paràsit asexual i implicat en la biosíntesi d’àncores GPI i N-glicans. Les GPI són la forma més destacada de glicosilació de proteïnes en P. falciparum i ancoren proteïnes essencials a la superfície del paràsit al llarg de les diferents etapes del seu cicle vital. Finalment, la N-glicosilació és un procés essencial en la majoria d’eucariotes que té lloc al reticle endoplasmàtic i que modula el plegament, l’estabilitat, el trànsit i la funció de les proteïnes expressades a la via secretora.
Els nostres resultats recents indiquen que la N-glicosilació és activa i essencial per a la supervivència de P. falciparum en els seus estadis asexuals intraeritrocítics. Sorprenentment, els paràsits amb una N-glicosilació alterada mostren un peculiar fenotip de "delayed death" (mort retardada), en què no deixen de replicar-se fins al segon cicle després de l’alteració. En particular, la "delayed death" s’ha descrit anteriorment en P. falciparum en relació amb inhibidors dirigits a l’apicoplast. La inesperada relació entre N-glicosilació i "morta retardada" planteja noves i interessants qüestions que mereixen una exploració en profunditat per la seva importància en la biologia i la supervivència del paràsit.
En aquesta proposta, mitjançant el cribratge virtual basat en prediccions d’estructures 3D i l’enginyeria genètica mediada per CRISPR-Cas9, validarem químicament i genèticament les tres vies esmentades com a dianes farmacològiques per al disseny de nous agents antimalàrics. Proposem centrar-nos en la identificació de nous compostos capaços d’aturar el creixement del paràsit mitjançant la inhibició d’aquestes vies. En resum, seguirem un enfocament de recerca bàsica amb l’objectiu d’identificar molècules molt necessàries capaces d’eliminar el paràsit de la malària a través de nous mecanismes d’acció.
Finançament total
247.500,00 €
Finançat pel Ministeri de Ciència i Innovació - Agència Estatal de Recerca. Referència: PID2022-137031OB-I00 Convocatòria: Projectes de Generació de Coneixement.

Our Team
Coordinador
-
LUIS IZQUIERDO LAZARO
Equip ISGlobal
-
Maria Pia Alberione Investigadora predoctoral -
ANGEL FENOLLAR COLLADO
-
Jonathan Ortega Tècnic de laboratori
-
MIRIAM RAMIREZ MORENO
-
Tais Romero Investigadora predoctoral
Altres projectes
R21 AI151459-01A1
Longitudinal Antibody Profiles Correlated with Protection from Malaria in Malawi
BASEMALVAC
Baseline host and environmental factors that impact pre-erythrocytic malaria vaccine (hypo)responsiveness in endemic regions
CLIMSOCTRYPBOL
Insight on climate and social participatory research for integral management of vectorborne zoonosis caused by Trypanosoma cruzi and Leishmania spp. in the Bolivian Gran Chaco.
VaMonoS
Unravelling the heterogoneity and function of monocytes in vaccination and immunity to malaria
VivaxEVTalk
Extracellular Vesicles as Intercellular Communicators and Biomarkers of Cryptic Erythrocytic Infections in Plasmodium vivax malaria
RESPONSE
Mechanisms of the transcriptional responses to changes in the environment in the malaria parasite Plasmodium falciparum
MalTransc
Transcriptional regulation of adaptation and developmental decisions in malaria parasites: from epigenetic variation to directed transcriptional responses
SMART
Identifying Severe Malaria with a new Aptamer-based Rapid diagnostic Test

